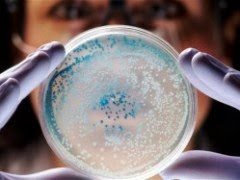

ΑΠΙΣΤΕΥΤΗ ANAKAΛΥΨΗ: Δημιούργησαν βενζίνη από μικρόβια!
Νοτιοκορεάτες επιστήμονες κατάφεραν για πρώτη φορά παγκοσμίως να αναπτύξουν βενζίνη από γενετικά τροποποιημένα μικρόβια.
Ειδικότερα, όπως ανακοινώθηκε, ερευνητές του προηγμένου Ινστιτούτου Επιστημών και Τεχνολογίας της Νοτίου Κορέας κατάφεραν να δημιουργήσουν επιτυχώς, μέσω της μεταβολικής μηχανικής, βακτήρια που καταναλώνουν γλυκόζη και παράγουν βενζίνη. Η μελέτη, με επικεφαλής τον Δρ. Lee Sang-yeop, δημοσιεύτηκε τη Δευτέρα στο επιστημονικό περιοδικό Nature. Η τεχνολογία παραγωγής καυσίμων με μικρόβια αναπτύχθηκε στις ΗΠΑ το 2010, ωστόσο μέχρι σήμερα είχε καταστεί δυνατή μόνο η σύνθεση αλκανίων με 13 ως 17 άτομα άνθρακα.
Τα αλκάνια είναι κορεσμένοι υδρογονάνθρακες που εντοπίζονται στο φυσικό αέριο και το πετρέλαιο. Δεν είναι δύσκολο να βρει κανείς ένα αλκάνιο με αρκετά άτομα άνθρακα στο φυσικό περιβάλλον, όμως η μετατροπή του φυσικού αλκανίου σε βενζίνη είναι δαπανηρή και χρονοβόρα. Ωστόσο, οι Νοτιοκορεάτες επιστήμονες κατάφεραν να αναπτύξουν, μέσω της μεταβολικής τροποποίησης βακτηριδίων E.coli, μόρια αλκανίων με 4 ως 12 άτομα άνθρακα, κατάλληλα να υποκαταστήσουν τη συμβατική βενζίνη.
Όπως επισημαίνουν οι επιστήμονες, τα αλκάνια που παράγονται με τη νέα τεχνική βιοσύνθεσης έχουν διαφορετική σύσταση από τη συμβατική βενζίνη, ωστόσο μπορούν να την υποκαταστήσουν σε όλες τις εφαρμογές της. Με ένα λίτρο διαλύματος με τροποποιημένα βακτήρια οι Νοτιοκορεάτες ερευνητές παρήγαγαν 580 ml βενζίνης. Όπως εξηγούν οι επιστήμονες, η αποδοτικότητα της νέας μεθόδου είναι ακόμα χαμηλή, ωστόσο η έρευνα είναι πολύ σημαντική γιατί κατάφερε να παράγει βενζίνη με μεταβολικά τροποποιημένα μικρόβια.
peiraxtiri